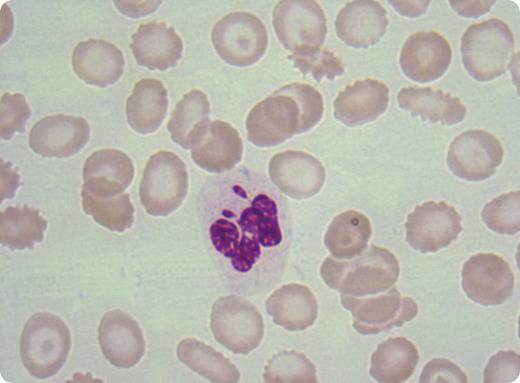
A 52-year-old woman presented with dyspnea, accompanied by anemia, thrombocytopenia, and leukocytosis. The peripheral blood showed blasts, promyelocytes, myelocytes, lymphocytes, and granulocytes, some of which had 2 drumstick-like appendages (shown). Bone marrow examination revealed myelodysplastic syndrome–myeloproliferative disorder (MDS-MPD) nonclassifiable. The presence of double drumsticks prompted a cytogenetic study that showed XXX. / The triple X syndrome, with a reported incidence of 1/1000 females, is associated with neurodevelopmental defects, but not with MDS-MPD or other hematologic disorders. The X inactivation center ensures that all but one X chromosome are randomly inactivated by epigenetic silencing. Once X inactivation has been established, the silent X chromosome is stably maintained in somatic cells and visible in blood smears of healthy women in up to 17% of neutrophils as a drumstick-shaped appendage. Two drumsticks in one cell was seen in this case of XXX, but it can be observed in other genetic disorders such as 48 XXXY. Finally, more than one drumstick can appear in acquired disorders such as MDS-MPD. / Retrospectively, the genotype of this woman was suspected by examining the blood smear, wherein 2 nuclear appendages depicted 2 inactivated X chromosomes.

A 52-year-old woman presented with dyspnea, accompanied by anemia, thrombocytopenia, and leukocytosis. The peripheral blood showed blasts, promyelocytes, myelocytes, lymphocytes, and granulocytes, some of which had 2 drumstick-like appendages (shown). Bone marrow examination revealed myelodysplastic syndrome–myeloproliferative disorder (MDS-MPD) nonclassifiable. The presence of double drumsticks prompted a cytogenetic study that showed XXX.
The triple X syndrome, with a reported incidence of 1/1000 females, is associated with neurodevelopmental defects, but not with MDS-MPD or other hematologic disorders. The X inactivation center ensures that all but one X chromosome are randomly inactivated by epigenetic silencing. Once X inactivation has been established, the silent X chromosome is stably maintained in somatic cells and visible in blood smears of healthy women in up to 17% of neutrophils as a drumstick-shaped appendage. Two drumsticks in one cell was seen in this case of XXX, but it can be observed in other genetic disorders such as 48 XXXY. Finally, more than one drumstick can appear in acquired disorders such as MDS-MPD.
Retrospectively, the genotype of this woman was suspected by examining the blood smear, wherein 2 nuclear appendages depicted 2 inactivated X chromosomes.
A 52-year-old woman presented with dyspnea, accompanied by anemia, thrombocytopenia, and leukocytosis. The peripheral blood showed blasts, promyelocytes, myelocytes, lymphocytes, and granulocytes, some of which had 2 drumstick-like appendages (shown). Bone marrow examination revealed myelodysplastic syndrome–myeloproliferative disorder (MDS-MPD) nonclassifiable. The presence of double drumsticks prompted a cytogenetic study that showed XXX.
The triple X syndrome, with a reported incidence of 1/1000 females, is associated with neurodevelopmental defects, but not with MDS-MPD or other hematologic disorders. The X inactivation center ensures that all but one X chromosome are randomly inactivated by epigenetic silencing. Once X inactivation has been established, the silent X chromosome is stably maintained in somatic cells and visible in blood smears of healthy women in up to 17% of neutrophils as a drumstick-shaped appendage. Two drumsticks in one cell was seen in this case of XXX, but it can be observed in other genetic disorders such as 48 XXXY. Finally, more than one drumstick can appear in acquired disorders such as MDS-MPD.
Retrospectively, the genotype of this woman was suspected by examining the blood smear, wherein 2 nuclear appendages depicted 2 inactivated X chromosomes.
Many Blood Work images are provided by the ASH IMAGE BANK, a reference and teaching tool that is continually updated with new atlas images and images of case studies. For more information or to contribute to the Image Bank, visit www.ashimagebank.org.